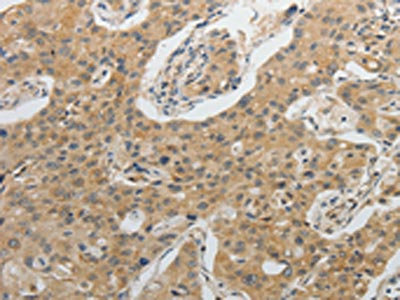

IL1B Antibody
-
中文名稱:IL1B兔多克隆抗體
-
貨號(hào):CSB-PA825267
-
規(guī)格:¥1100
-
圖片:
-
The image on the left is immunohistochemistry of paraffin-embedded Human lung cancer tissue using CSB-PA825267(IL1B Antibody) at dilution 1/20, on the right is treated with fusion protein. (Original magnification: ×200)
-
The image on the left is immunohistochemistry of paraffin-embedded Human lymphoma tissue using CSB-PA825267(IL1B Antibody) at dilution 1/20, on the right is treated with fusion protein. (Original magnification: ×200)
-
Gel: 10%SDS-PAGE, Lysate: 40 μg, Lane: Mouse testis tissue, Primary antibody: CSB-PA825267(IL1B Antibody) at dilution 1/100, Secondary antibody: Goat anti rabbit IgG at 1/8000 dilution, Exposure time: 1 second
-
-
其他:
產(chǎn)品詳情
-
Uniprot No.:
-
基因名:
-
別名:Catabolin antibody; H1 antibody; IFN beta inducing factor antibody; IL 1 antibody; IL 1 beta antibody; IL-1 beta antibody; IL1 antibody; IL1 BETA antibody; IL1B antibody; IL1B_HUMAN antibody; IL1F2 antibody; Interleukin 1 beta antibody; Interleukin 1 beta precursor antibody; interleukin 1; beta antibody; Interleukin-1 beta antibody; OAF antibody; Osteoclast activating factor antibody; OTTHUMP00000162031 antibody; Preinterleukin 1 beta antibody; Preinterleukin beta antibody; Pro interleukin 1 beta antibody
-
宿主:Rabbit
-
反應(yīng)種屬:Human,Mouse
-
免疫原:Fusion protein of Human IL1B
-
免疫原種屬:Homo sapiens (Human)
-
標(biāo)記方式:Non-conjugated
-
抗體亞型:IgG
-
純化方式:Antigen affinity purification
-
濃度:It differs from different batches. Please contact us to confirm it.
-
保存緩沖液:-20°C, pH7.4 PBS, 0.05% NaN3, 40% Glycerol
-
產(chǎn)品提供形式:Liquid
-
應(yīng)用范圍:ELISA,WB,IHC
-
推薦稀釋比:
Application Recommended Dilution ELISA 1:2000-1:5000 WB 1:200-1:1000 IHC 1:25-1:100 -
Protocols:
-
儲(chǔ)存條件:Upon receipt, store at -20°C or -80°C. Avoid repeated freeze.
-
貨期:Basically, we can dispatch the products out in 1-3 working days after receiving your orders. Delivery time maybe differs from different purchasing way or location, please kindly consult your local distributors for specific delivery time.
-
用途:For Research Use Only. Not for use in diagnostic or therapeutic procedures.
相關(guān)產(chǎn)品
靶點(diǎn)詳情
-
功能:Potent proinflammatory cytokine. Initially discovered as the major endogenous pyrogen, induces prostaglandin synthesis, neutrophil influx and activation, T-cell activation and cytokine production, B-cell activation and antibody production, and fibroblast proliferation and collagen production. Promotes Th17 differentiation of T-cells. Synergizes with IL12/interleukin-12 to induce IFNG synthesis from T-helper 1 (Th1) cells. Plays a role in angiogenesis by inducing VEGF production synergistically with TNF and IL6.
-
基因功能參考文獻(xiàn):
- a genome wide association study for "high" gingival crevicular fluid IL-1beta expression among 4910 European-American adults and identify association signals in the IL37 locus, is reported. PMID: 30206230
- Treatment with 30 microg/ml curcumin significantly down-regulated mRNA expression of IL-1beta (p < .05) and protein production of IL-6 (p < .05) in M1 macrophages from Behcet's disease patients but not in M1 macrophage from controls. PMID: 29806793
- pp65 mediates human cytomegalovirus immune evasion through downmodulation of IL-1beta. PMID: 30332797
- The children in the acute phase of Kawasaki disease had a significantly higher level of IL-1beta than the healthy control group . PMID: 30022755
- circSEMA4B serves as a miR-431 sponge to compete with SFRP1 or GSK-3beta for miR-431 binding, thus inhibiting IL-1beta-induced nucleus pulposus degenerative process in intervertebral disc degeneration. PMID: 30251693
- IL-1beta-511TT genotype may influence the development of antiretroviral-associated hepatotoxicity and its severity in alcohol and nevirapine users independently and in combination. PMID: 29849489
- Impairment in TNF, IL-1beta, and IL-17 production upon stimulation with mycobacterial antigens may contribute to the increased susceptibility to M. tuberculosis infection observed in HTLV-1 infected individuals. PMID: 29523325
- rs16944 minor A allele less frequent in type-2 diabetes mellitus PMID: 28634744
- This study demonstrated significant differences in the blood levels of IL-1 beta between people with epilepsy and healthy subjects. PMID: 30140987
- Polymorphisms of IL-1betab and TNF-a are not a risk of ICC, but an individual with O. viverrini infection has an effect on all genotypes of the TNF-alpha gene that might promote intrahepatic cholangiocarcinoma . Primary prevention of intrahepatic cholangiocarcinoma in high-risk areas is based on efforts to reduce O. viverrini infection. PMID: 30139338
- Melatonin inhibits epithelialtomesenchymal transition in gastric cancer cells via attenuation of IL1beta/NFkappaB/MMP2/MMP9 signaling. PMID: 30066836
- Study findings suggest that both promoter and exon polymorphisms of IL-1B gene have a significant role in the risk of developing Graves' disease (GD), whereas IL-1RN-VNTR variant has no association with GD in North India Kashmiri population. PMID: 29454070
- The IL-6 expression was consistently associated with necrotizing fasciiitis severity, whereas IL1B had the strongest association with 30-day mortality. PMID: 28176831
- Taken together, the silencing of H4R inhibited the H4R mediated Mast cell functions and SAPK/JNK phosphorylation. Furthermore, the H4R activation utilized SAPK/JNK signaling pathway for IL-1beta release in HMC-1 cells PMID: 29863427
- IL-1beta/IL-6 network is highly expressed in the colorectal cancer (CRC) microenvironment, indicating that this network is important in the progression of CRC PMID: 29803656
- Colombian individuals with high African ancestry proportions at locus 2q14 harbour more IL1B-CGTC copies and are consequently at an increased risk of colorectal cancer. PMID: 28157220
- Study found a statistically significant association between the IL-1B rs16944 polymorphism and febrile seizures (FS) risk in Caucasians and Asians. The TT+CT genotypes were associated with a 1.43 times increased risk for FS in Caucasians, while an increased risk of 1.39 times was observed for FS development for the TT homozygotes in Asians. PMID: 29808330
- Preincubation of LAD2 cells with the natural flavonoid methoxyluteolin (1-100 mM) inhibits (P < 0.0001) secretion and gene expression of IL-1beta, procaspase-1, and pro-IL-1beta. Mast cell secretion of IL-1beta in response to SP and IL-33 reveals targets for the development of antiinflammatory therapies. PMID: 30232261
- in Caco-2 CFTR-shRNA cells, the EGFR ligand EREG is overexpressed due to an active IL-1beta autocrine loop that indirectly activates EGFR, constituting new signaling effectors for the CFTR signaling pathway, downstream of CFTR, Cl(-) , and IL-1beta. PMID: 29091309
- Caspase-1-dependent IL-1beta processing and secretion require the AIM2 inflammasome pathway in human dental pulp cells and the AIM2 inflammasome pathway is critical for regulation of the dental pulp immune response. PMID: 29178062
- Genetic Polymorphisms of IL1B, IL6, and TNFalpha in a Chinese Han Population with Pulmonary Tuberculosis. PMID: 29888256
- Our results demonstrate that in the early stage of sepsis, JMJD3 contributes to high levels of neutrophil mPR3 expression and thereby to the production of the inflammatory cytokine IL-1beta PMID: 29621735
- In the current study, we found a clear inflammagenesis gene signature in COPD small airway epithelium, with increased gene expression of CCL2, CCL7, IL1B and IL1R2 in lung small airway epithelial cells. We provide evidence for IL1B as a novel player in inflammation. PMID: 29616282
- The results of this study suggested that rs16944 of IL-1 beta may act as a risk factor for multiple system atrophy. PMID: 29251119
- IL-1 role in cardiovascular diseases [review] PMID: 29549570
- Sendai Virus V Protein Inhibits the Secretion of Interleukin-1beta by Preventing NLRP3 Inflammasome Assembly. PMID: 30021903
- This study suggested that -511 C/T (rs16944) and -31 C/T (rs1143627) polymorphisms in IL-1beta gene may not be involved in RPL in Iranian Azeri women. Also the promoter polymorphism of the IL-1RN gene may not play a role in the susceptibility to RPL. PMID: 29281611
- IL-1beta and CTHRC1 are upregulated in patients with Osteoarthritis. PMID: 29393342
- our observations indicated that IL-1beta-mediated NF-kappaB signaling augments the osteosarcoma cell growth via modulating MiR-376c/TGFA axis PMID: 29441940
- Insulin resistance correlates positively with IL-1beta among non-diabetic hemodialysis patients. PMID: 29436520
- The baseline concentrations of IL-6 and IL-1beta were significantly higher in the Major Depressive Disorder group than those in the control group. There was no significant difference of TNF-alpha between the two groups. PMID: 29587166
- The genetic association between the studied SNPs of the IL-1beta gene and recurrent apththous stomatitis remains controversial and requires further investigation. PMID: 28942153
- The rs16944 TT genotype of Il-1 beta is associated with mesial temporal lobe epilepsy with hippocampal sclerosis development what may be explained by the higher IL-1beta levels produced by this genotype. PMID: 28675059
- Our meta-analysis proved that IL-1beta + 3954C/T is associated with MI susceptibility, especially among Caucasian populations. PMID: 30045312
- In this longitudinally monitored male population, observed effect of baseline central adiposity on future periodontitis progression is conditional on proinflammatory IL-1 genetic variations. PMID: 27541081
- In Pakistani population, an increased risk of gastric cancer development is associated with the carriage of IL-1B-511*T and IL-1RN*2 alleles PMID: 28110439
- This study revealed that the P2X7R/NLRP3 pathway plays important roles in IL-1beta secretion and inhibition of Toxoplasma gondii proliferation in small intestinal epithelial cells. PMID: 29291748
- These results indicate that tumorderived IL1beta enhanced stromal glycolysis and induced oneway lactate flow from the tumor mesenchyme to transformed epithelium, which promotes oral squamous cell carcinoma cell proliferation PMID: 29207019
- Therefore, the common allergen Der f1 was not only found to induce allergy, but also led to pyroptosis and IL1beta secretion via the NLRP3caspase1 inflammasome in human bronchial epithelial cells PMID: 29207030
- Increased production of IL-1beta in the gut-associated lymphoid tissue and peripheral blood of HIV infected patients. PMID: 29672590
- IL-1beta is involved in the regulation of OPN levels during respiratory syncytial virus infection. PMID: 29677209
- Sequencing results of samples from different individuals discovered that polymorphisms on the loci 154 and 486 significantly increased the risks of obstructive sleep apnea syndrome and affected IL-1beta protein expression. However, we did not conduct in-depth research PMID: 28742193
- sauchinone inhibited inflammatory response in IL-1beta-stimulated human chondrocytes probably through inhibiting the activation of NF-kappaB signaling pathway. These data suggest that sauchinone may be a potential agent in the treatment of OA. PMID: 29356224
- VPS4B might facilitate chondrocyte apoptosis in Osteoarthritis via p38 MAPK signaling pathway. PMID: 28744712
- this study shows that IL-1beta limits the level of NK cell activation by inducing apoptosis and suppression as a homeostatic regulatory function PMID: 27086951
- Higher IL-1beta levels are associated with post-stroke depression at 2 weeks in the presence of the -511T allele with a borderline significant interaction term and with any +3953C/T polymorphism without a significant interaction term. PMID: 28844626
- In multivariate analysis, the IL1B rs16944 TT and TNF rs1799964 TC genotypes were significantly associated with intrauterine cytomegalovirus infection. Twenty-two out of 72 congenitally infected newborns had confirmed sensorineural hearing loss. Carriers of CT or TT genotype of CCL2 rs13900 had increased risk of hearing loss at birth and at 6 months of age. PMID: 28501927
- TNFalpha and IL-1beta mediated expression of E-selectin preferentially attract sialyl Lewis(X) mediated mucosal-associated invariant T cell migration into the synovial fluid of rheumatoid arthritis patients. PMID: 28756336
- These data indicate a process of NF-kappaB-induced miR-506 suppression and JAG1 upregulation upon IL-1beta induction. PMID: 28926924
- Effective IL1beta and CCL2 antagonists are currently in clinical review to treat benign inflammatory disease, and their transition to the cancer clinic could have a rapid impact PMID: 28790030
顯示更多
收起更多
-
亞細(xì)胞定位:Cytoplasm, cytosol. Lysosome. Secreted, extracellular exosome. Secreted.
-
蛋白家族:IL-1 family
-
組織特異性:Expressed in activated monocytes/macrophages (at protein level).
-
數(shù)據(jù)庫鏈接:
Most popular with customers
-
YWHAB Recombinant Monoclonal Antibody
Applications: ELISA, WB, IHC, IF, FC
Species Reactivity: Human, Mouse, Rat
-
Phospho-YAP1 (S127) Recombinant Monoclonal Antibody
Applications: ELISA, WB, IHC
Species Reactivity: Human
-
-
-
-
-
-